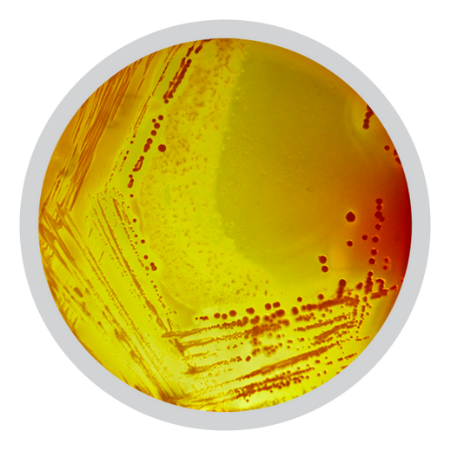

About us
The Mérieux Legacy
At Mérieux Nutrisciences, we leverage over 50 years of scientific and entrepreneurial expertise to answer food industry needs.
Today’s global challenges transform the way food is produced, marketed and consumed, which is why we know our clients need more than reliable analytical results; they need practical and innovative solutions that will contribute to make food systems safer, healthier and more sustainable.
From our initial expertise in microbiology and consulting, we have broadened our scope of scientific specialties into chemistry, education, certification, research, labelling, and sensory in order to offer a complete suite of services to meet our customers’ needs.
Today, we offer comprehensive solutions to support our clients, from product development to market suitability, while contributing to consumers’ health worldwide.
Present worldwide, we are more than 100 accredited laboratories and a team of over 8,000 committed employees.
We strongly believe that together, we can create solutions to offer our planet:
BETTER FOOD. BETTER HEALTH. BETTER WORLD.
About Mérieux NutriSciences
An integral part of Institut Mérieux (headquartered in Lyon of France) and established in 1967, Mérieux NutriSciences as a leading worldwide of standard quality services to the food and nutrition value chain, is dedicated to protecting consumers’ health throughout the world, by delivering a wide range of testing and consulting services to the food & nutrition industries, and to water & environment, agro-chemistry, consumer goods, pharmaceuticals and cosmetics companies. With 50 years of experience in food safety and quality, Mérieux NutriSciences is now present in about 27 countries with 100 laboratories, in addition 6 R&D centers in the US, Canada, Italy, France, Brazil and China, more than 8,000 employees.